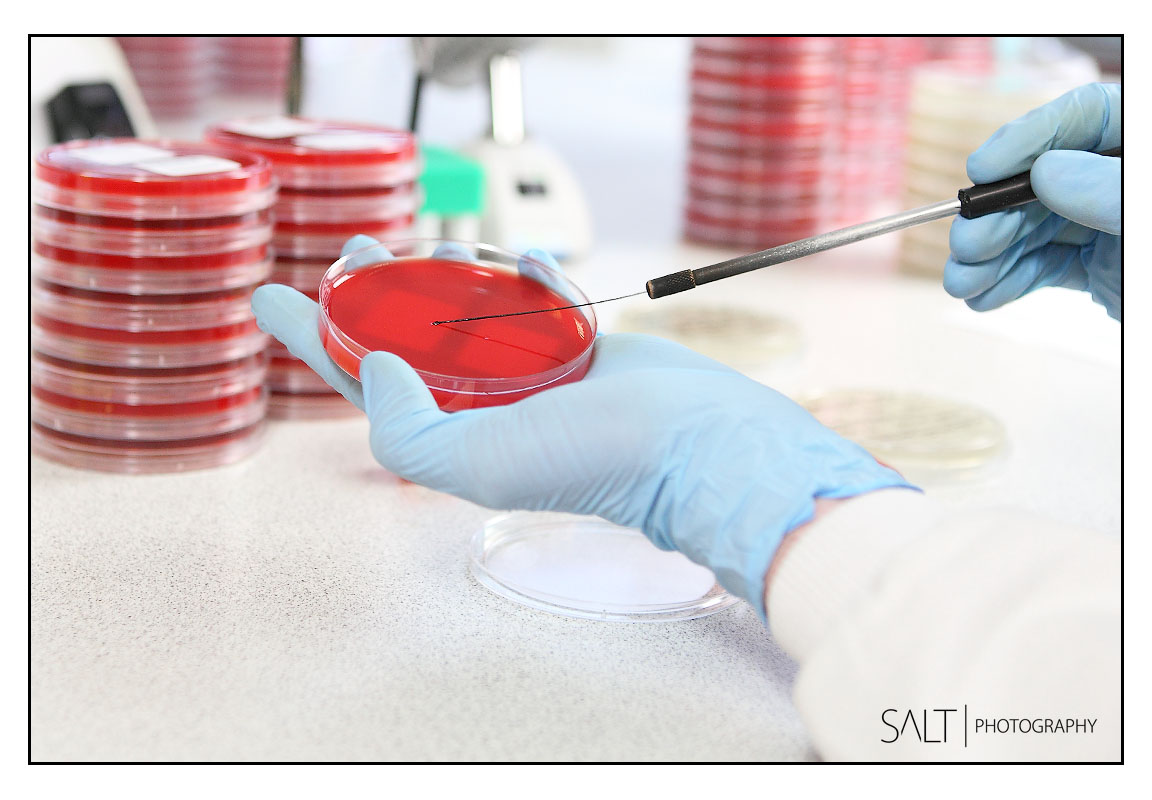
Digital Marketing Photography In Harrogate Leeds York
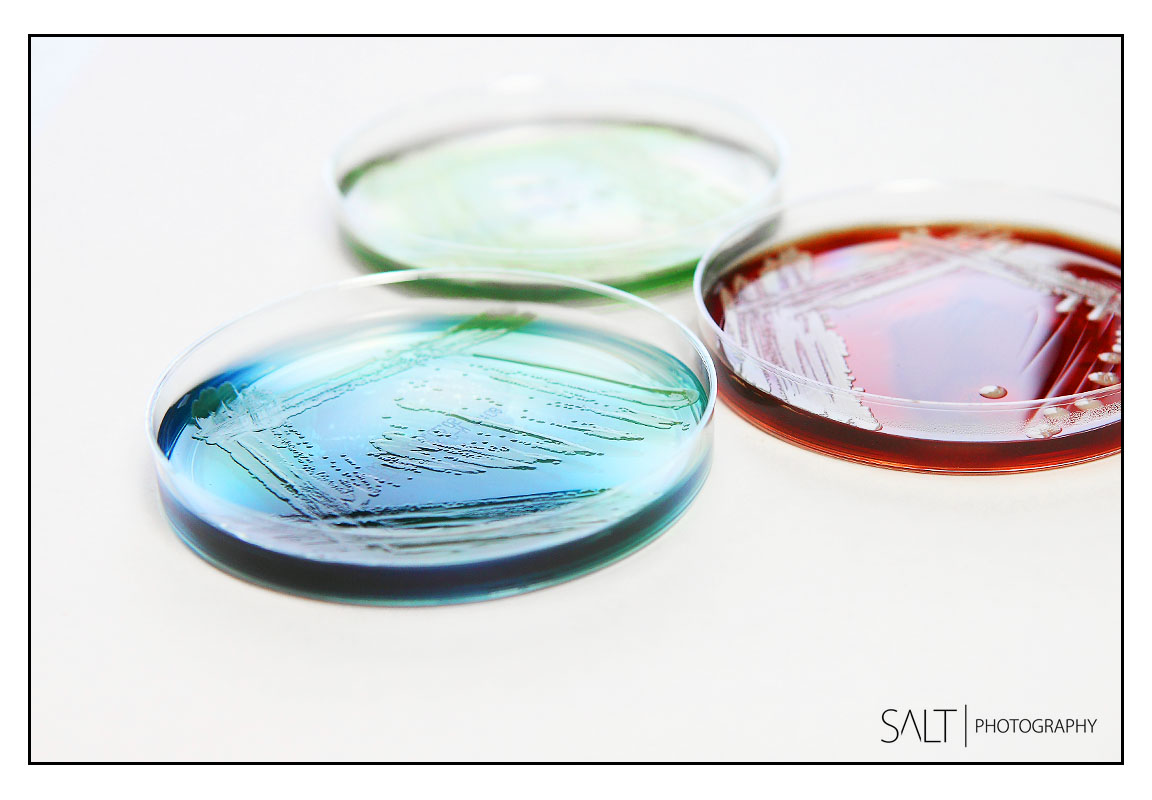
Digital Marketing Photographer In Leeds Area

marketing photography - image library
"build a professional stock image library for your business so you have images ready for advertising, marketing, internal & external comms and press releases"
client photo shoot details
This project required a range of stock images that captured and visually documented a set number of processes and procedures that take place in their labs.
The final image library fed into a number of regular direct trade marketing and online marketing activites. The images also became a key part of printed trade packs and promotional material used at conferences and trade shows.